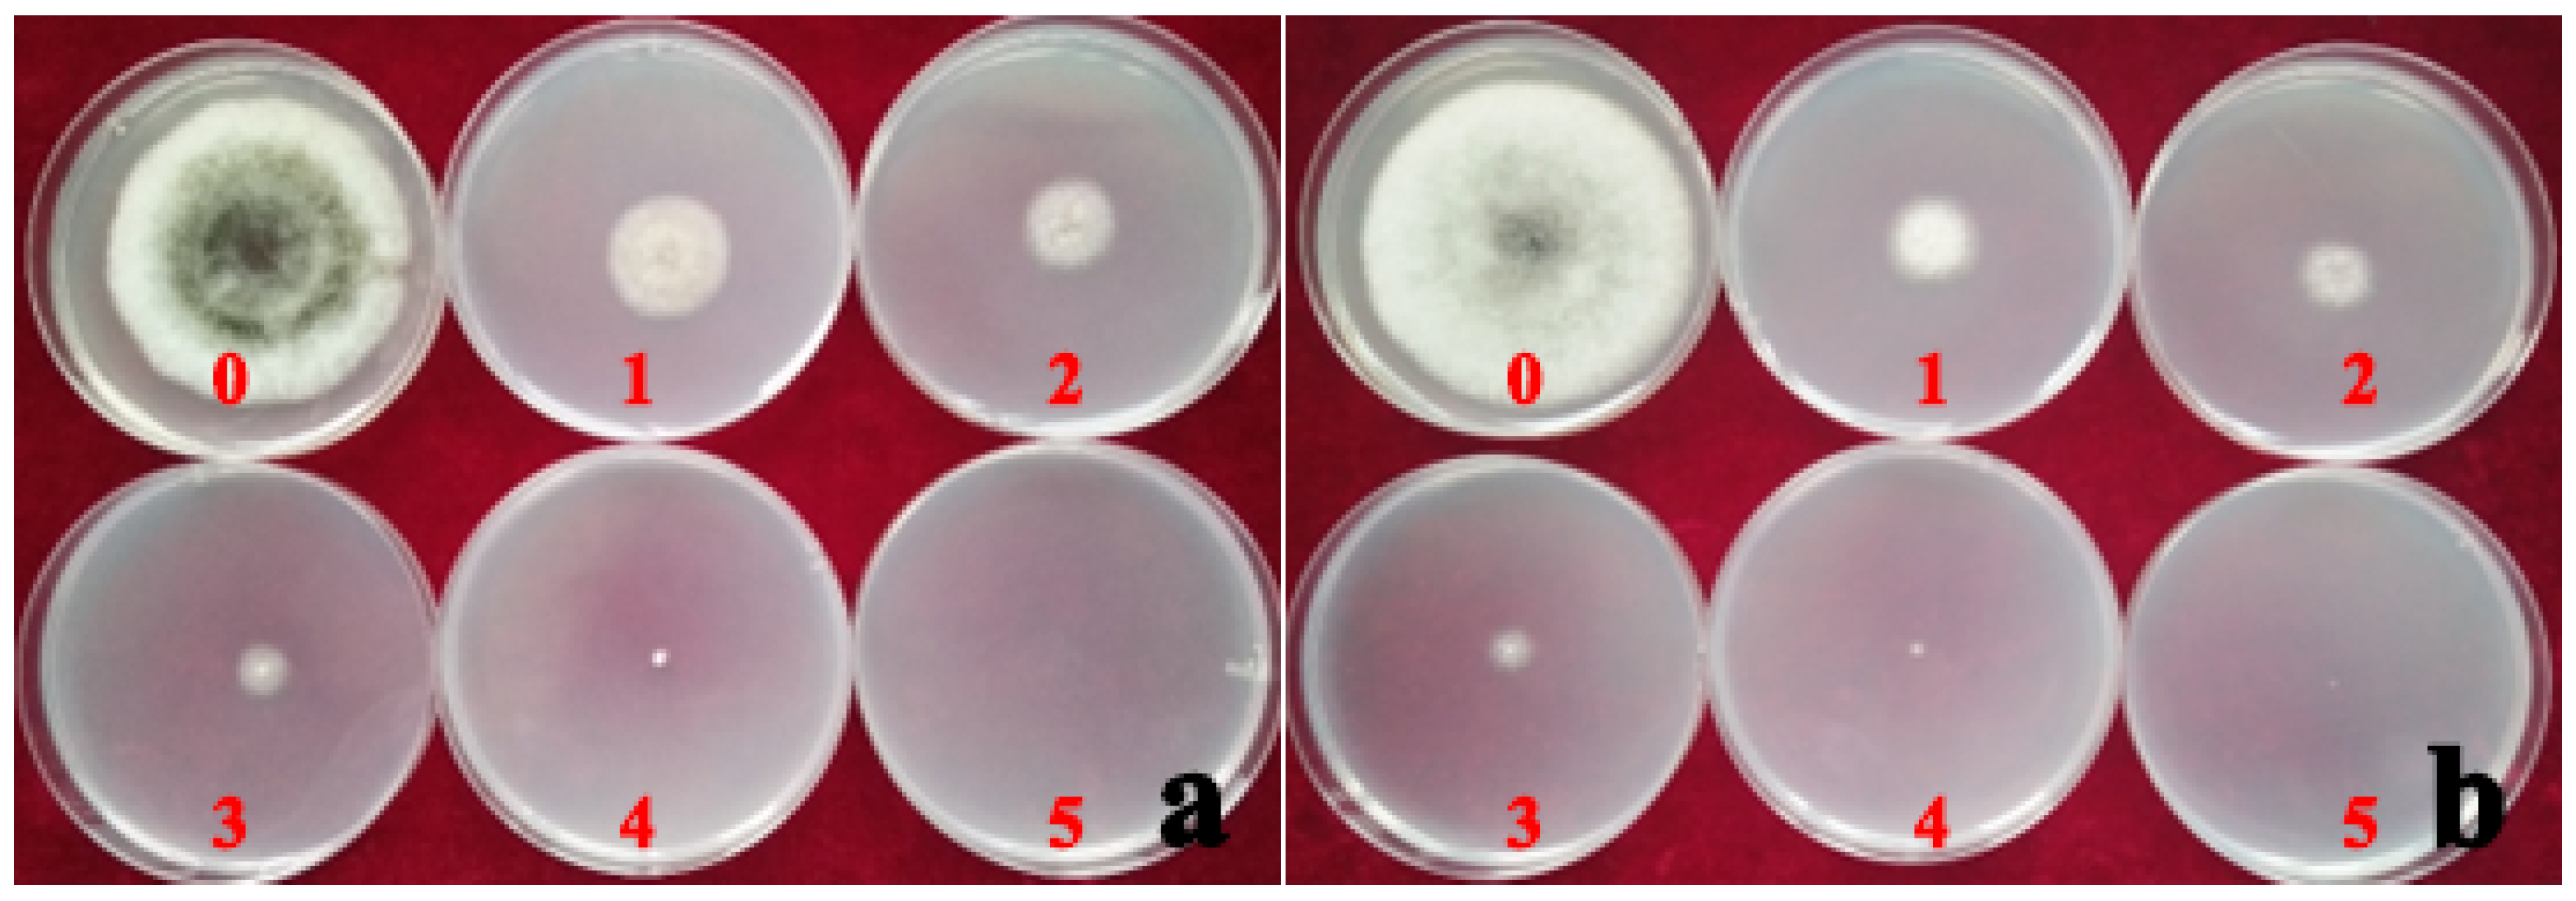
Jof 09 01062 g007

Luobuma Leaf Spot Disease Caused by Alternaria tenuissima in China
Abstract
:1. Introduction
2. Materials and Methods
2.1. Disease Survey
2.2. Sample Collection and Isolation
2.3. Morphological and Biological Characterization
2.4. DNA Extraction, Polymerase Chain Reaction (PCR), Sequencing and Phylogenetic Analysis
2.5. Pathogenicity Test
2.6. Fungicide Virulence Test
3. Results
3.1. Symptoms of Leaf Spot Disease
3.2. Disease Survey
3.3. Morphological Characteristics of A. tenuissima
3.4. Biological Characteristics
3.5. DNA Sequencing and Phylogenetic Analysis
3.6. Pathogenicity Testing
3.7. Fungicide Virulence Test
4. Discussion
5. Conclusions
Author Contributions
Funding
Institutional Review Board Statement
Informed Consent Statement
Data Availability Statement
Conflicts of Interest
References
- Berljand, S.S. Agro-Technology of Kendir; NAUK: Moscow, Russia, 1950. [Google Scholar]
- Xie, W.; Zhang, X.; Wang, T.; Hu, J. Botany, traditional uses, phytochemistry and pharmacology of Apocynum venetum L. (Luobuma): A review. J. Ethnopharmacol. 2012, 141, 1–8. [Google Scholar] [CrossRef] [PubMed]
- Jiang, Y.; Li, B.T. China Botanical Records; Science Press: Beijing, China, 1977. [Google Scholar]
- Gao, P.; Duan, T.Y.; Christensen, M.J.; Nan, Z.B.; Liu, Q.T.; Meng, F.J.; Huang, J.F. The occurrence of rust disease, and biochemical and physiological responses on Apocynum venetum plants grown at four soil water contents, following inoculation with Melampsora apocyni. Eur. J. Plant Pathol. 2018, 150, 549–563. [Google Scholar] [CrossRef]
- Gao, P.; Duan, T.Y.; Nan, Z.B.; Christensen, M.J.; Liu, Q.T.; Meng, F.J.; Huang, J.F. The influence of irrigation frequency on the occurrence of rust disease (Melampsora apocyni) and determination of the optimum irrigation regime in organic Apocynum venetum production. Agric. Water Manag. 2018, 205, 81–89. [Google Scholar] [CrossRef]
- Gao, P.; Duan, T.Y.; Nan, Z.B.; O’Connor, P.J. First report of Septoria apocyni causing spot blight on the species of Apocynum venetum and Poacynum pictum in China. Plant Dis. 2014, 98, 1429. [Google Scholar] [CrossRef]
- Gao, P.; Duan, T.Y.; Nan, Z.B. Alternaria catharanthicola causes black leaf spot of Apocynum venetum in China. Plant Dis. 2017, 101, 634. [Google Scholar] [CrossRef]
- Lan, Y.R.; Li, T.; Duan, T.Y.; Gao, P. Effects of pappus removal and low-temperature short-term storage on interspecific and intraspecific variation in seed germination of Luobuma. Seed Sci. Technol. 2019, 47, 13–24. [Google Scholar] [CrossRef]
- Lan, Y.R.; Duan, T.Y. Characterization of Boeremia exigua causing stem necrotic lesions on Luobuma in northwest China. Sci. Rep. 2022, 12, 21609. [Google Scholar] [CrossRef]
- Pitt, J.I.; Hocking, A.D. Fungi and Food Spoilage; Academic Press: Sydney, Australia, 1997. [Google Scholar]
- Zheng, H.H.; Zhao, J.; Wang, T.Y.; Wu, X.H. Characterization of Alternaria species associated with potato foliar diseases in China. Plant Pathol. 2015, 64, 425–433. [Google Scholar] [CrossRef]
- Wang, T.; Zhao, J.; Sun, P.; Wu, X. Characterization of Alternaria species associated with leaf blight of sunflower in China. Eur. J. Plant Pathol. 2014, 140, 301–315. [Google Scholar] [CrossRef]
- Hong, S.G.; Cramer, R.A.; Lawrence, C.B.; Pryor, B.M. Alt a1 allergen homologs from Alternaria and related taxa: Analysis of phylogenetic content and secondary structure. Fungal Genet. Biol. 2005, 42, 119–129. [Google Scholar] [CrossRef]
- Myresiotis, C.K.; Karaoglanidis, G.S.; Vryzas, Z.; Papadopoulou-Mourkidou, Z. Evaluation of plant-growth-promoting rhizobacteria, acibenzolar-S-methyl and hymexazol for integrated control of Fusarium crown and root rot on tomato. Pest Manag. Sci. 2011, 68, 404–411. [Google Scholar] [CrossRef] [PubMed]
- Payne, P.A.; Williams, G.E. Hymexazol treatment of sugar-beet seed to control seedling disease caused by Pythium spp. and Aphanomyces cochlioides. Crop Prot. 1990, 93, 371–377. [Google Scholar] [CrossRef]
- Tian, Y.L.; Jiang, X.L.; Ji, J.H.; Zhu, C.X. Development and optimization of the chemically defined medium composition for ZSM production by Streptomyces lavendulae var. hainanensisn. Chin. J. Antibiot. 2010, 35, 189–193. [Google Scholar]
- Wang, J.J.; Chen, T.X.; Wei, X.K.; Kamran, M.; White, J.F.; Zhao, G.Q.; Li, C.J. Evaluation of different antimicrobial agents for laboratory and field against Pantoea agglomerans, the causative agent of bacterial leaf blight disease on oat (Avena sativa). Plant Pathol. 2023. [Google Scholar] [CrossRef]
- Song, X.M.; Zhu, X.Y.; Li, T.; Liang, C.; Zhang, M.; Shao, Y.; Tao, J.; Sun, R.F. Dehydrozingerone inspired discovery of potential broad-spectrum fungicidal agents as ergosterol biosynthesis inhibitors. J. Agric. Food Chem. 2019, 67, 11354–11363. [Google Scholar] [CrossRef]
- Wang, Q.; Zhang, C.; Long, Y.; Wu, X.; Su, Y.; Lei, Y.; Ai, Q. Bioactivity and control efficacy of the novel antibiotic tetramycin against various kiwifruit diseases. Antibiotics 2021, 10, 289. [Google Scholar] [CrossRef] [PubMed]
- Gao, P.; Nan, Z.B.; Christensen, M.J.; Barbetti, M.J.; Duan, T.Y.; Liu, Q.T.; Meng, F.J.; Huang, J.F. Factors influencing rust (Melampsora apocyni) intensity on cultivated and wild Apocynum venetum in Altay Prefecture, China. Phytopathology 2019, 109, 593–606. [Google Scholar] [CrossRef]
- Simmons, E.G. Alternaria: An Identification Manual; CBS Fungal Biodiversity Centre: Utrecht, The Netherlands, 2007. [Google Scholar]
- Tao, Y.; Zeng, F.; Ho, H.; Wei, J.; Wu, Y.; Yang, L.; He, Y. Pythium vexans causing stem rot of Dendrobium in Yunnan province, China. J. Phytopathol. 2011, 159, 255–259. [Google Scholar] [CrossRef]
- White, T.J.; Bruns, T.; Lee, S.; Taylor, J. Amplification and direct sequencing of fungal ribosomal RNA genes for phylogenetics. In PCR Protocols: A Guide to Methods and Applications; Innis, M.A., Gelfand, D.H., Spinsky, T.J., White, T.J., Eds.; Academic Press: New York, NY, USA, 1990; pp. 315–322. [Google Scholar]
- Berbee, M.L.; Pirseyedi, M.; Hubbard, S. Cochliobolus phylogenetics and the origin of known, highly virulent pathogens, inferred from ITS and glyceraldehyde-3-phosphate dehydrogenase gene sequences. Mycologia 1999, 159, 964–977. [Google Scholar] [CrossRef]
- Jacobs, K.; Bergdahl, D.R.; Wingfield, M.J.; Halik, S.; Seifert, K.A.; Bright, D.E.; Wingfield, B.D. Leptographium wingfieldii introduced into North America and found associated with exotic Tomicus pimiperda and native bark beetles. Mycol. Res. 2004, 108, 411–418. [Google Scholar] [CrossRef]
- Kumar, S.; Stecher, G.; Tamura, K. MEGA7: Molecular evolutionary genetics analysis version 7.0 for bigger datasets. Mol. Biol. Evol. 2016, 33, 1870–1874. [Google Scholar] [CrossRef] [PubMed]
- Kgatle, M.G.; Truter, M.; Ramusi, T.M.; Flett, B.; Aveling, T.A.S. Alternaria alternata, the causal agent of leaf blight of sunflower in South Africa. Eur. J. Plant Pathol. 2018, 151, 677–688. [Google Scholar] [CrossRef]
- Wei, X.K.; Xue, L.H.; Li, C.J. The first report of leaf spot caused by Alternaria alternata on Italian ryegrass (Lolium multiflorum) in China. Plant Dis. 2021, 105, 1211. [Google Scholar] [CrossRef] [PubMed]
- Lawrence, D.P.; Gannibal, P.B.; Peever, T.L.; Pryor, B.M. The sections of Alternaria: Formalizing species-group concepts. Mycologia 2013, 105, 530–546. [Google Scholar] [CrossRef] [PubMed]
- Gilardi, G.; Matic, S.; Gullino, M.L.; Garibaldi, A. First report of Alternaria alternata causing leaf spot on Spinach (Spinacia oleracea) in Italy. Plant Dis. 2019, 103, 2133. [Google Scholar] [CrossRef]
- Wei, M.; Chen, J.M.; Fu, B.Z.; Li, G.Y.; Wang, X.S. First report of brown leaf blight of Shenguyou (Staphylea bumalda) caused by Alternaria alternata in China. Plant Dis. 2018, 102, 2034. [Google Scholar] [CrossRef]
- Wee, J.I.; Park, J.H.; Back, C.G.; You, Y.H.; Chang, T. First report of leaf spot caused by Alternaria tenuissima on black chokeberry (Aronia melanocarpa) in Korea. Mycobiology 2016, 44, 187–190. [Google Scholar] [CrossRef]
- Zhang, X.; Jiang, B.; Wang, R.; Li, Y.; Sun, L. Occurrence of leaf spot of Begonia semperflorens caused by Alternaria tenuissima in China. Plant Dis. 2020, 8, 104. [Google Scholar] [CrossRef]
- Ma, J.; Li, H.; Wang, X.; Guo, M. Alternaria tenuissima causing fruit scab disease on Actinidia chinensis in Anhui province, China. Plant Dis. 2020, 104, 569. [Google Scholar] [CrossRef]
- Zheng, H.H.; Wu, X.H. First report of Alternaria blight of potato caused by Alternaria tenuissima in China. Plant Dis. 2013, 97, 1246. [Google Scholar] [CrossRef]
- Carbone, I.; Kohn, L.M. A method for designing primer sets for speciation studies in flamentous ascomycetes. Mycologia 1999, 91, 553–556. [Google Scholar] [CrossRef]
- Gou, Y.N.; Aung, S.L.L.; Htun, A.A.; Huang, C.X.; Deng, J.X. Alternaria species in section Alternaria associated with Iris plants in China. Front. Plant Microbiol. 2022, 13, 1036950. [Google Scholar] [CrossRef] [PubMed]
- Woudenberg, J.H.; Seidl, M.F.; Groenewald, J.Z.; de Vries, M.; Stielow, J.B.; Thomma, B.P.; Crous, P.W. Alternaria section Alternaria: Species, formae speciales or pathotypes? Stud. Mycol. 2015, 82, 1–21. [Google Scholar] [CrossRef] [PubMed]
- Cai, Z.Y.; Liu, Y.X.; Shi, Y.P.; Dai, L.M.; Li, L.L.; Mu, H.J.; Lv, M.L.; Liu, X.Y. Alternaria yunnanensis sp. nov., a new Alternaria species causing foliage spot of Rubber tree in China. Mycobiology 2019, 30, 66–75. [Google Scholar] [CrossRef]
- Bessadat, N.; Hamon, B.; Henni, D.E.; Simoneau, P. First report of tomato early blight caused by Alternaria grandis in Algeria. Plant Dis. 2016, 100, 533. [Google Scholar] [CrossRef]
- Moumni, M.; Allagui, M.B.; Mancini, V.; Murolo, S.; Tarchoun, N.; Romanazzi, G. Morphological and molecular identification of seedborne fungi in Squash (Cucurbita maxima, Cucurbita moschata). Plant Dis. 2020, 104, 1335–1350. [Google Scholar] [CrossRef]
- Li, Y.; Zhang, D.; Xu, W.; Wu, Z.; Cao, A. Alternaria tenuissima causing leaf spot and fruit rot on pepper (Capsicum annuum): First report in China. New Dis. Rep. 2011, 24, 3. [Google Scholar] [CrossRef]
- Fu, R.; Chen, C.; Wang, J.; Ke, Y.; Lu, D. Identification of Alternaria tenuissima causing brown leaf spot on Paris polyphylla var. chinensis in China. J. Phytopathol. 2019, 167, 440–444. [Google Scholar] [CrossRef]
- Nasehi, A.; Kadir, J.B.; Abidin, M.; Wong, M.Y.; Mahmodi, F. First report of Alternaria tenuissima causing leaf spot on eggplant in Malaysia. Plant Dis. 2012, 96, 1226. [Google Scholar] [CrossRef]
- Lee, J.H.; Kim, D.S.; Cho, H.J.; Gang, G.H.; Kwak, Y.S. First report of leaf spot in Farfugium japonicum caused by Alternaria tenuissima in Korea. Plant Dis. 2013, 97, 1382. [Google Scholar] [CrossRef]
- Bensassi, F.; Zid, M.; Rhouma, A.; Bacha, H.; Hajlaoui, M.R. First report of Alternaria species associated with black point of wheat in Tunisia. Ann. Microbiol. 2009, 59, 465–467. [Google Scholar] [CrossRef]
- Lin, Q.; Sun, X.T.; He, H.; Yang, D.X. First report of leaf spot caused by Alternaria tenuissima on Avicennia marina in China. Plant Dis. 2016, 100, 2323. [Google Scholar] [CrossRef]
- Song, X.B.; Cui, Y.P.; Peng, A.T.; Ling, J.F.; Chen, X. First report of brown spot disease in Psidium guajava caused by Alternaria tenuissima in China. J. Plant Pathol. 2020, 102, 1309. [Google Scholar] [CrossRef]
- Gao, P.; Nan, Z.B.; Wu, Y.N.; Liu, Q.T.; Meng, F.J.; Xiao, Z.C.; Duan, T.Y. Characteristics photosynthetic physiology and growth with 8 Luobuma ecotypes in the Apocynum and Poacynum from Altay of Xinjiang, China. Acta Botonica Boreali Occident. Sinaca 2015, 35, 2069–2077. [Google Scholar]
- Rotem, J. The genus Alternaria: Biology, epidemiology, and pathogenicity. Biol. Epidemiol. Pathog. 1994, 89, 347. [Google Scholar]
- Andrew, M.; Peever, T.L.; Pryor, B.M. An expanded multilocus phylogeny does not resolve morphological species within the small-spored Alternaria species complex. Mycologia 2009, 101, 95–109. [Google Scholar] [CrossRef]
- Tymon, L.S.; Peever, T.L.; Johnson, D.A. Identification and enumeration of small-spored Alternaria species associated with potato in the US northwest. Plant Dis. 2016, 100, 465–472. [Google Scholar] [CrossRef] [PubMed]
- Siciliano, I.; Gilardi, G.; Ortu, G.; Gisi, U.; Gullino, M.L.; Garibaldi, A. Identification and characterization of Alternaria species causing leaf spot on cabbage, cauliflower, wild and cultivated rocket by using molecular and morphological features and mycotoxin production. Eur. J. Plant Pathol. 2017, 149, 401–413. [Google Scholar] [CrossRef]
- Bai, Y.B.; Zhang, A.L.; Tang, J.J.; Gao, J.M. Synthesis and antifungal activity of 2-Chloromethyl-1H-benzimidazole derivatives against phytopathogenic fungi in vitro. J. Agric. Food Chem. 2013, 61, 2789–2795. [Google Scholar] [CrossRef]
- Tang, H.Y.; Zhang, Q.; Li, H.; Gao, J.M. Antimicrobial and allelopathic metabolites produced by Penicillium brasilianum. Nat. Prod. Res. 2015, 29, 345–348. [Google Scholar] [CrossRef]
- Wang, Y.; Huang, D.; Cheng, Y.X. Structural optimization, fungicidal activities evaluation, DFT study and structure-activity relationship of dopamine derivatives with benzothiazole fragment from Polyrhachis dives. Chem. Biodivers. 2023, 20, e202300533. [Google Scholar] [CrossRef] [PubMed]
- Wang, S.; Bao, L.; Wang, W.; Song, D.; Wang, J.; Cao, X. Heterocyclic pyrrolizinone and indolizinones derived from natural lactam as potential antifungal agents. Fitoterapia 2018, 129, 257–266. [Google Scholar] [CrossRef] [PubMed]
- Ren, Y.; Li, D.; Jiang, S.; Wang, Y.; Tang, Q.; Huang, H.; Wang, D.; Song, B.; Chen, Z. Integration of transcriptomic and proteomic data reveals the possible action mechanism of the antimicrobial ZSM against Didymella segeticola, the causal agent of tea leaf spot. Phytopathology 2021, 111, 2238–2249. [Google Scholar] [CrossRef] [PubMed]
- Jiang, X.; Zhu, C.; Ji, J.; Sun, D.; Wei, G.; Tian, Y. Mechanism of zhongshengmycin in control of Xanthomonas oryzae pv. oryzae. Chin. J. Biol. Control 2003, 19, 69–72. [Google Scholar]
- Wang, Q.; Lin, M.; Shen, P.; Guan, Y. Elevation of fatty acid biosynthesis metabolism contributes to Zhongshengmycin resistance in Xanthomonas oryzae. Antibiotics 2021, 10, 1166. [Google Scholar] [CrossRef]
- Tao, H.; Wang, H.; Huang, S.X.; Zhang, Y.; Zhang, Z.H.; Liu, W.; Shi, N.X.; Zhu, F.; Ji, Z.L.; Chen, X.R. Identification and characterization of Diaporthe eres causing leaf blight disease on the medicinal herb Polygonatum sibiricum. J. Gen. Plant Pathol. 2020, 86, 468–476. [Google Scholar] [CrossRef]

| Growth Conditions | AvAt-2 | PhAt-3 | |
|---|---|---|---|
| LA | 50.75 ± 0.32 C b | 57.00 ± 0.46 C a | |
| CDA | 43.25 ± 0.48 D a | 47.88 ± 0.22 D a | |
| Culture media | OA | 68.25 ± 1.89 A a | 72.88 ± 0.43 A a |
| PSA | 67.00 ± 0.54 A a | 69.88 ± 1.09 A a | |
| PDA | 62.63 ± 0.80 B a | 63.00 ± 0.35 B a | |
| Starch | 54.13 ± 1.30 B b | 58.50 ± 0.54 A a | |
| Fructose | 53.37 ± 1.86 B a | 51.50 ± 0.20 B a | |
| Carbon source | Sucrose | 52.63 ± 1.32 B a | 51.37 ± 0.20 B a |
| Glucose | 60.50 ± 0.96 A a | 61.00 ± 1.34 A a | |
| NaCl | 44.75 ± 0.83 C b | 49.38 ± 0.97 B a | |
| NH4NO3 | 39.63 ± 1.07 C b | 45.00 ± 0.35 D a | |
| KNO3 | 53.25 ± 0.43 B a | 53.50 ± 0.46 B a | |
| Nitrogen source | NaNO3 | 51.50 ± 0.50 B a | 51.00 ± 0.89 C a |
| Beef extract | 69.25 ± 0.32 A a | 65.38 ± 0.55 A b | |
| NaCl | 53.50 ± 0.74 B a | 54.63 ± 0.38 B a | |
| 5 | 30.63 ± 1.07 D b | 37.50 ± 0.41 F a | |
| 6 | 50.25 ± 0.32 C a | 50.88 ± 0.77 E a | |
| 7 | 56.75 ± 0.25 B a | 56.25 ± 0.52 D a | |
| pH values | 8 | 57.38 ± 0.24 B b | 59.13 ± 0.13 C a |
| 9 | 57.38 ± 0.38 B b | 59.50 ± 0.46 C a | |
| 10 | 58.00 ± 0.35 B b | 61.75 ± 0.32 B a | |
| 11 | 70.63 ± 0.55 A b | 74.00 ± 0.20 A a | |
| 5 | 16.10 ± 0.14 G b | 17.30 ± 0.17 F a | |
| 10 | 29.00 ± 0.90 F a | 30.80 ± 0.69 E a | |
| 15 | 52.10 ± 0.31 D a | 53.30 ± 1.05 D a | |
| Temperatures (℃) | 20 | 81.20 ± 0.50 B a | 82.20 ± 0.89 B a |
| 25 | 85.60 ± 0.95 A a | 86.00 ± 1.15 A a | |
| 30 | 72.20 ± 0.92 C a | 72.60 ± 1.58 C a | |
| 35 | 34.40 ± 0.56 E a | 31.20 ± 0.53 E b |
| Species | Strains | Hosts/Substrates | Genbank Accessions | Literature | |||
|---|---|---|---|---|---|---|---|
| ITS | gpd | TEF | H3 | ||||
| A. arborescens | PPRI:11433 | Helianthus annuus | MF381794 | MF381768 | MF381820 | - | [27] |
| bas_G1 | - | - | - | - | MK239225 | - | |
| A. alternata | PPRI:13478 | H. annuus | MF381802 | MF381776 | MF381828 | - | [27] |
| HMCH-9 | Lolium multiflorum | MH567106 | MH567107 | MH567109 | - | [28,29] | |
| BC1 | Brassica carinata | - | - | - | KY548070 | [29] | |
| AltSpin2_18 | Spinacia oleracea | - | - | - | MK085979 | [30] | |
| ZZHB-710 | Staphylea bumalda | - | - | - | MF991905 | [31] | |
| A. tenuissima | 15-245 | Aronia melanocarpa | LC134324 | LC134319 | LC136865 | - | [32] |
| QHT3 | Begonia semperflorens | MN264615 | MN977123 | MN256108 | - | [33] | |
| KAC-3 | Actinidia chinensis | - | - | - | MN395834 | [34] | |
| GS-ATA2 | Solanum tuberosum | - | - | - | JX495167 | [35] | |
| A. gaisen | CBS 118488 | Pyrus pyrifolia | KP124427 | KP124278 | KP125206 | - | [36] |
| CBS 632.93 | Pyrus pyrifolia | KC584197 | KC584116 | KC584658 | - | [36] | |
| A. alstroemeriae | CBS 118808 | Alstroemeria sp. | KP124296 | KP124153 | KP125071 | - | [37] |
| A. betae-kenyensis | CBS 118810 | Beta vulgaris var. cicla | KP124419 | KP124270 | KP125197 | - | [36] |
| A. eichhorniae | CBS 119778 | Eichhornia crassipes | KP124426 | KP124277 | KP125205 | - | [37] |
| A. burnsii | CBS 118817 | Tinospora cordifolia | KP124424 | KP124274 | KP125202 | - | [36] |
| A. gossypina | CBS 102597 | Minneola tangelo | KP124432 | KP124281 | KP125211 | - | [36] |
| A. iridiaustralis | CBS 118404 | Iris sp. | KP124434 | KP124283 | KP125213 | - | [37] |
| A. jacinthicola | CBS 878.95 | Arachis hypogaea | KP124437 | KP124286 | KP125216 | - | [36] |
| A. longipes | CBS 121332 | Nicotiana tabacum | KP124443 | KP124292 | KP125222 | - | [38] |
| A. tomato | CBS 103.30 | Solanum lycopersicum | KP124445 | KP124294 | KP125224 | - | [36] |
| A. daucifolii | CBS 118812 | Daucus carota | KC584193 | KC584112 | KC584652 | - | [37] |
| A. calendulae | CBS 224.76 | Calendula officinalis | KJ718127 | KJ717977 | KJ718475 | - | [29] |
| A. nitrimali | CBS 109163 | Solanum viarum | KJ718201 | JQ646358 | KJ718547 | - | [29] |
| A. dichondrae | CBS 199.74 | Dichondra repens | KJ718166 | JQ646357 | KJ718514 | - | [29] |
| A. agripestis | CBS 577.94 | Euphorbia esula | KJ718099 | JQ646356 | KJ718448 | - | [29] |
| A. acalyphicola | CBS 541.94 | Acalypha indica | KJ718097 | JQ646355 | KJ718446 | - | [29] |
| A. tropica | CBS 631.93 | Passiflora edulis | KJ718261 | JQ646354 | KJ718607 | - | [29] |
| A. cirsinoxia | CBS 113261 | Cirsium arvense | KJ718143 | KJ717993 | KJ718491 | - | [39] |
| A. henanensis | JZB3180070 | - | MW793897 | MW818009 | MW818083 | - | - |
| A. guizhouensis | JZB3180067 | - | MW793894 | MW818006 | MW818080 | - | - |
| A. linariae | NB242 | Solanum tuberosum | KT968774 | KR911762 | KT937248 | - | [40] |
| A. solani | NB266 | - | KT968777 | KR911753 | KT937258 | - | - |
| A. tenuissima | AvAt-1 | A. venetum | OR602905 | OR603956 | OR672518 | OR603950 | In this study |
| AvAt-2 | A. venetum | OR602906 | OR603957 | OR672519 | OR603951 | In this study | |
| AvAt-3 | A. venetum | OR602907 | OR603958 | OR672520 | OR603952 | In this study | |
| PhAt-1 | P. hendersonni | OR602908 | OR603959 | OR672521 | OR603953 | In this study | |
| PhAt-2 | P. hendersonni | OR602909 | OR603960 | OR672522 | OR603954 | In this study | |
| PhAt-3 | P. hendersonni | OR6029010 | OR603961 | OR672523 | OR603955 | In this study | |
| Fusarium solani | F174 | Cucurbita maxima | - | - | - | MK497772.1 | [41] |
| AvAt-2 | PhAt-3 | |||||
|---|---|---|---|---|---|---|
| Fungicides | Regression equation | Correlation coefficient | EC50/ mg/L | Regression equation | Correlation coefficient | EC50/ mg/L |
| Hymexazol | y = 2.7368x − 1.4447 | 0.9894 | 226.38 | y = 2.3167x − 0.053 | 0.9925 | 151.75 |
| ZSM | y = 0.5275x + 3.3771 | 0.7148 | 1192.86 | y = 0.4850x + 1.8790 | 0.7435 | 987.96 |
| Fungicides | The Concentration of Fungicides | AvAt-2 | PhAt-3 |
|---|---|---|---|
| 58 | 58.35 ± 0.25 E b | 62.42 ± 0.17 E a | |
| 117 | 61.68 ± 1.66 D b | 71.53 ± 0.53 D a | |
| hymexazol | 233 | 75.40 ± 0.80 C b | 81.53 ± 0.43 C a |
| 467 | 88.10 ± 0.52 B b | 94.08 ± 0.53 B a | |
| 933 | 98.18 ± 0.23 A a | 98.40 ± 0.00 A a | |
| 17 | 12.00 ± 0.17 C b | 20.00 ± 2.16 B a | |
| 33 | 11.28 ± 0.98 C b | 18.33 ± 4.14 B a | |
| ZSM | 67 | 11.75 ± 0.17 C b | 24.18 ± 2.60 B a |
| 133 | 17.58 ± 0.34 B b | 24.18 ± 2.60 B a | |
| 267 | 37.43 ± 0.36 A b | 43.73 ± 2.09 A a |
Disclaimer/Publisher’s Note: The statements, opinions and data contained in all publications are solely those of the individual author(s) and contributor(s) and not of MDPI and/or the editor(s). MDPI and/or the editor(s) disclaim responsibility for any injury to people or property resulting from any ideas, methods, instructions or products referred to in the content. |
© 2023 by the authors. Licensee MDPI, Basel, Switzerland. This article is an open access article distributed under the terms and conditions of the Creative Commons Attribution (CC BY) license (https://creativecommons.org/licenses/by/4.0/).
Share and Cite
Lan, Y.; Yan, Z.; Duan, T. Luobuma Leaf Spot Disease Caused by Alternaria tenuissima in China. J. Fungi 2023, 9, 1062. https://doi.org/10.3390/jof9111062
Lan Y, Yan Z, Duan T. Luobuma Leaf Spot Disease Caused by Alternaria tenuissima in China. Journal of Fungi. 2023; 9(11):1062. https://doi.org/10.3390/jof9111062
Chicago/Turabian StyleLan, Yanru, Zhichen Yan, and Tingyu Duan. 2023. "Luobuma Leaf Spot Disease Caused by Alternaria tenuissima in China" Journal of Fungi 9, no. 11: 1062. https://doi.org/10.3390/jof9111062
APA StyleLan, Y., Yan, Z., & Duan, T. (2023). Luobuma Leaf Spot Disease Caused by Alternaria tenuissima in China. Journal of Fungi, 9(11), 1062. https://doi.org/10.3390/jof9111062
